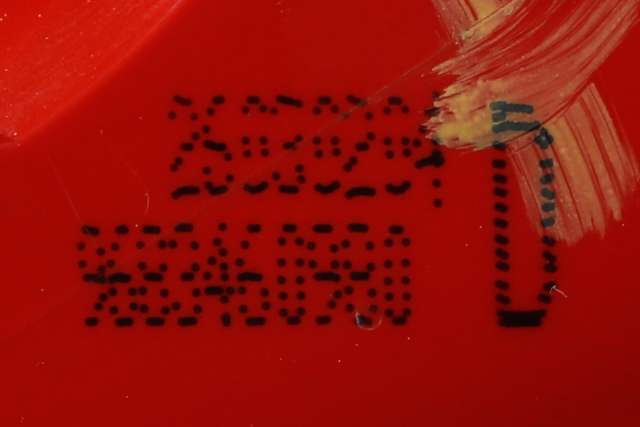

|
|

|
| Klikk for større bilde |
|
| Informasjon om delen | |
|---|---|
| Delnr | 363154 |
| Delenavn | BAKLYKT HØYRE INDRE |
| Deleprodusent | PEUGEOT |
| Orig.delenummer | 96 834609 80 |
| Kvalitet | |
| Opplysninger | |
| Informasjon om bilen som delen er demontert fra | |
|---|---|
| Bilmerke | Peugeot |
| Biltype | 3008, 2009-2016 (Type I) |
| Årsmodell | 2010 |
| KmStand | 172000 |
| Karosseri | SUV COMBI |
| Farge | HVIT: KWED |
| Motorstr | 1.6HDI |
| Motor | 9HZ, 109HK |
| Gir | 5 TR MAN |
| Chassisnummer | VF30U9HZH9S232794 |
|

|

|

|

|

|

|
| Klikk for alle deler lagerført fra denne bilen... |